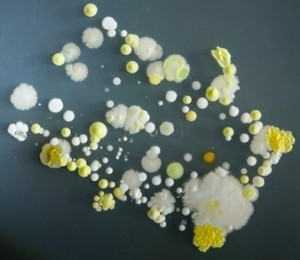
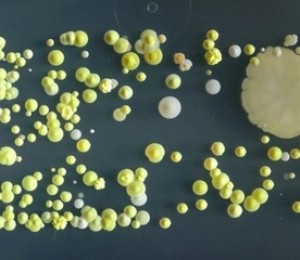
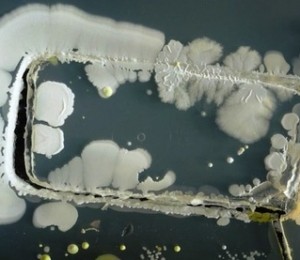

Un experiment realizat la un colegiu britanic a dezvaluit ca telefoanele mobile sunt gazdele ideale pentru colonii intregi de bacterii.
Studentii de la Universitatea din Surrey si-au "scufundat" telefoanele mobile in vase speciale de laborator (asa numitele vase Petri, lamele pentru analiza culturilor de celule), scrie presa straina, iar ecranele tactile par sa fie in intregime acoperite de microbi si germeni.
Acest lucru sugereaza ca, la fel ca in cazul alimentelor si tastaturilor de calculator, bacterii pot sa fie gazduite si pe suprafata unui telefon mobil (touch screen) si, prin urmare, pot fi transmise prin contact.
Lectorul specializat in biologie moleculara, Dr. Simon Park, a explicat intr-un comunicat de presa ca bacteriile de pe telefonul fiecarei persoane contin un istoric, iar acest istoric arata aproape toate lucrurile pe care un individ le-a atins in trecutul recent.
"Din aceste rezultate, se pare ca telefonul mobil nu isi aminteste doar numere de telefon, dar in acelasi timp el gazduieste un istoric al contactului nostru personal si fizic, cum ar fi atunci cand luam contact cu alti oameni, impuritati si alte materii", spune specialistul in biologie moleculara.
Desi s-a descoperit ca majoritatea bacteriilor de pe telefoanele mobile sunt inofensive, adica nu ne transmit boli, o mica cantitate din bacteriile numite "Staphylococcus aureus" (stafilococul auriu) a fost descoperita pe aceste gadgeturi. Aceasta bacterie poate provoca infectii si de obicei isi face un "camin" in interiorul nasului uman. Asa ca o persoana se poate scobi in nas pentru a transfera, fara sa isi dea seama, bacteriile si germenii pe un telefon mobil.
Fiecare imagine de mai jos arata o mare adunare de bacterii acolo unde este localizat de obicei butonul de "home", aratand astfel germenii si microbii care sunt "gazduiti" de degetul mare. Sursa.
Citeste si: Cum sa dezinfectezi jucariile copilului tau intr-un minut, fara niciun efort
Cate milioane de microbi sunt transferati de fiecare data cand te saruti
TOP 10 cele mai infricosatoare locuri de munca

Deficienta de magneziu - Cum o recunosti
Pastele reincalzite, mai sanatoase decat cele proaspat gatite


















